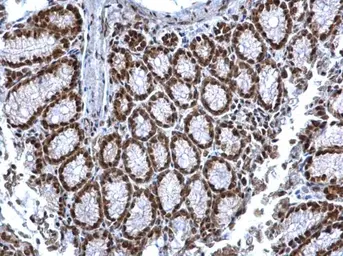
Anti-SIN3A antibody used in IHC (Paraffin sections) (IHC-P). GTX129156

SIN3A antibody
Cat. No. GTX129156
Cat. No. GTX129156
-
HostRabbit
-
ClonalityPolyclonal
-
IsotypeIgG
-
ApplicationsWB ICC/IF IHC-P IP ChIP assay
-
ReactivityHuman, Mouse, Rat